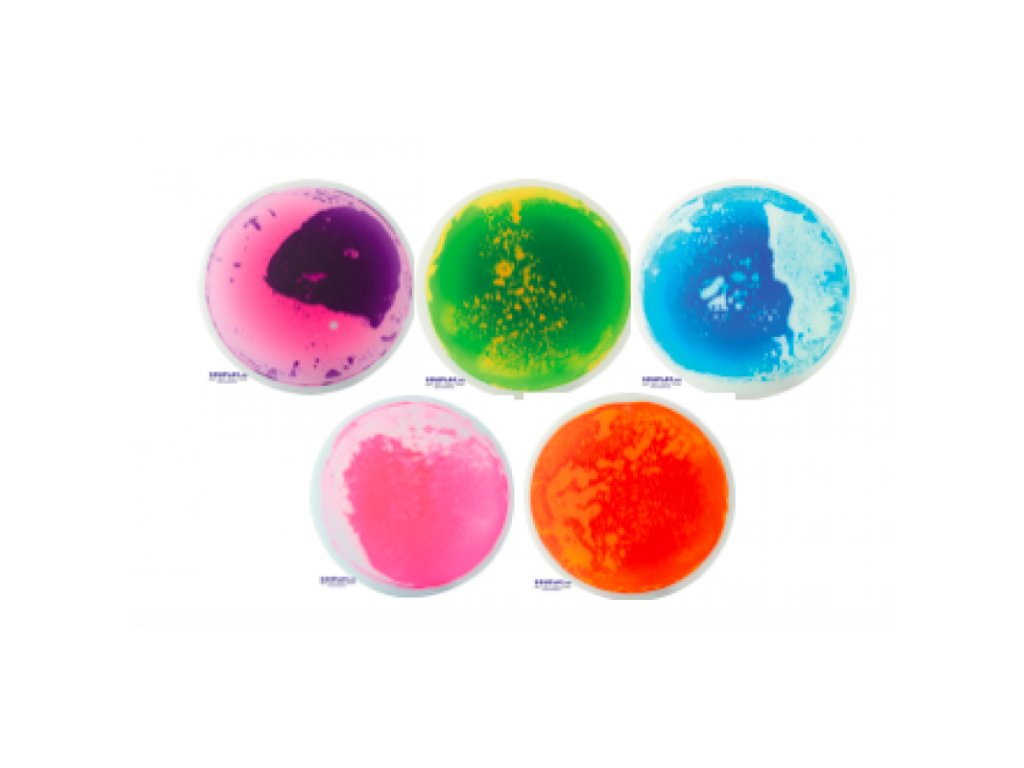

Smyslová dlažba Mega
Pomocí tlaku rukou a nohou mění tato dlažba svou strukturu a má uklidňující funkci na dítě.




Pomocí tlaku rukou a nohou mění tato dlažba svou strukturu a má uklidňující funkci na dítě. Podložky sou naplněné hustou kosmetickou tekutinou (absolutně nejedovatou) a mají protiskluzovou spodní stranu. Gelová vrstva o síle 3,5 mm je obzvláště odolná proti poškrábání a oděru. Podložky jsou vhodné pro cvičení na posílení koncentrace a rovnováhy: stoj na jedné noze, pomalé přešlapování z jedné nohy na druhou, naklánění podložky špičkou chodidla... a pro pouhou zábavu. Celkem 5 kulatých podložek různých barev. Nosnost jedné dlažby je 90 kg. Rozměr 40 x 40.
Doplňkové parametry
| Kategorie: | Dlažba, chodník, dráha |
|---|---|
| EAN: | 110374 |
Diskuze
Buďte první, kdo napíše příspěvek k této položce.